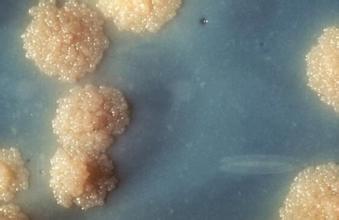

男性患上梅毒应该怎么治疗

2015-07-20 上海九龙男子医院
吴先生,38岁。几年前随朋友出来打工,妻子不在身边,一人在外面难免会孤独难耐,快速在朋友的纵容下,进入红灯区,不久便龟头、包皮出现瘙痒、皮疹、分泌物增多并迅速化脓溃烂,吴先生立马意识到不对,怀疑自己是不是患上了梅毒,这才在朋友的介绍下来到上海九龙医院接受治疗。
通过在医院的详细检查后,医生告诉他,他患的是二期梅毒伴混合菌感染性包皮龟头炎。
梅毒分一期、二期、三期和潜伏梅毒,不同时期的症状也会有所不同的,早期可能会比较的轻微也没有什么疼痛感,患者们容易麻痹,没加注意,等发展到二期时就比较严重了,所以一定要及时到医院检查治疗,吴先生的二期梅毒还不算太严重。
治疗办法:上海九龙医院推出“基因诱导特异性抗病毒免疫综合疗法”,该疗法立足于多联、立体综合治疗理念,被称为体系强大、技术涵盖面广泛、具有个性化、中西结合好、疗效显着、治疗患者多、患者值得信赖的治疗体系。效果显着、快速、有效。
基因诱导特异性抗病毒免疫疗法采用患者自身疣体或脱落细胞(无症状患者可提取携带病毒体液或体细胞),对病毒进行定型、定量检测后,利用基因工程技术对其进行人工减毒、灭活、基因重组等处理,诱导患者自体免疫细胞增殖,形成大量能特异性识别病毒及其感染细胞的抗体,将其回输患者自身后,对体内病毒进行准确性、特异性、主动式攻击,高效靶向性杀灭血液中和细胞内的病毒,同时提升免疫力,防止病毒反复和转移,安全没有副作用。
三大突破成就行业领跑者
突破一:新技术,攻克反复难题
基因诱导抗病毒免疫综合疗法采用新的基因科研成果,突破现有常规治疗技术诸多缺陷,从根本上打破了尖锐湿疣和生殖器疱疹“治疗-反复-再治疗”的怪圈。
突破二:快速有效,3-5天清除病毒
基因诱导抗病毒免疫综合疗法更为快速有效,一般8小时症状开始缓解,3-5天症状自然脱落、消失,治疗一段时间就可以有效康复,并能有效避免再反复。
突破三:规范治疗,避免治疗不当
基因诱导抗病毒免疫综合疗法拥有严格的治疗规范,并形成了专业个性病治疗规范,避免出现胡乱用药、长期用药、治疗不当的现象。
上海九龙医院医生提醒:梅毒患者应当积极治疗。另外,一期、二期梅毒传染性较强,注意传染给别人,患者也要及时配合治疗。
相关文章:







